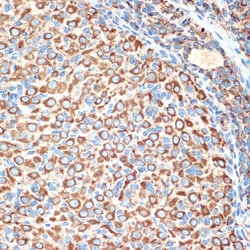
Invitrogen SLIT2 Recombinant Rabbit Monoclonal Antibody (1T5A3) 100 &mu;L;

Learn More
Invitrogen™ SLIT2 Recombinant Rabbit Monoclonal Antibody (1T5A3)
Rabbit Recombinant Monoclonal Antibody
Brand: Invitrogen™ MA542813
Description
Positive test controls include: 293T, PC-3, Mouse lung, Mouse brain, Mouse kidney, Rat brain. The target is usually found in the following locations: Secreted. Immunogen sequence: GHGGVLCDEE EDLFNPCQAI KCKHGKCRLS GLGQPYCECS SGYTGDSCDR EISCRGERIR DYYQKQQGYA ACQTTKKVSR LECRGGCAGG QCCGPLRSKR R.
SLIT2 are ligands for Robo receptors and play a vital role for axonal migration/navigation during neural development. A number of cleavage products through alternate splicing are reported in the literature for SLIT2 proteins. The C-terminal cleavage proteins are more diffusible than the larger N-terminal protein that is more tightly cell associated. SLIT2 protein is expressed in tissues such as fetal lung, kidney, and adult spinal cord.
Specifications
| SLIT2 | |
| Recombinant Monoclonal | |
| 1.9 mg/mL | |
| PBS with 0.05% BSA, 50% glycerol and 0.02% sodium azide; pH 7.3 | |
| O94813, Q9R1B9, Q9WVC1 | |
| SLIT2 | |
| A synthetic peptide corresponding to a sequence within amino acids 1400-1500 of human Slit2 (O94813). | |
| 100 μL | |
| Primary | |
| Human, Mouse, Rat | |
| Antibody | |
| IgG |
| ELISA, Immunohistochemistry (Paraffin), Western Blot | |
| 1T5A3 | |
| Unconjugated | |
| SLIT2 | |
| downregulated during adipocyte differentiation-1; Drad-1; E030015M03Rik; E130320P19Rik; mKIAA4141; neurogenic extracellular slit protein; SLIL3; Slit; slit guidance ligand 2; slit homolog 2 (Drosophila); slit homolog 2 protein; Slit homolog 2 protein C-product; Slit homolog 2 protein N-product; SLIT2; Slit-2; Slit2 protein | |
| Rabbit | |
| Affinity Chromatography | |
| RUO | |
| 20563, 360272, 9353 | |
| -20°C, Avoid Freeze/Thaw Cycles | |
| Liquid |
Your input is important to us. Please complete this form to provide feedback related to the content on this product.